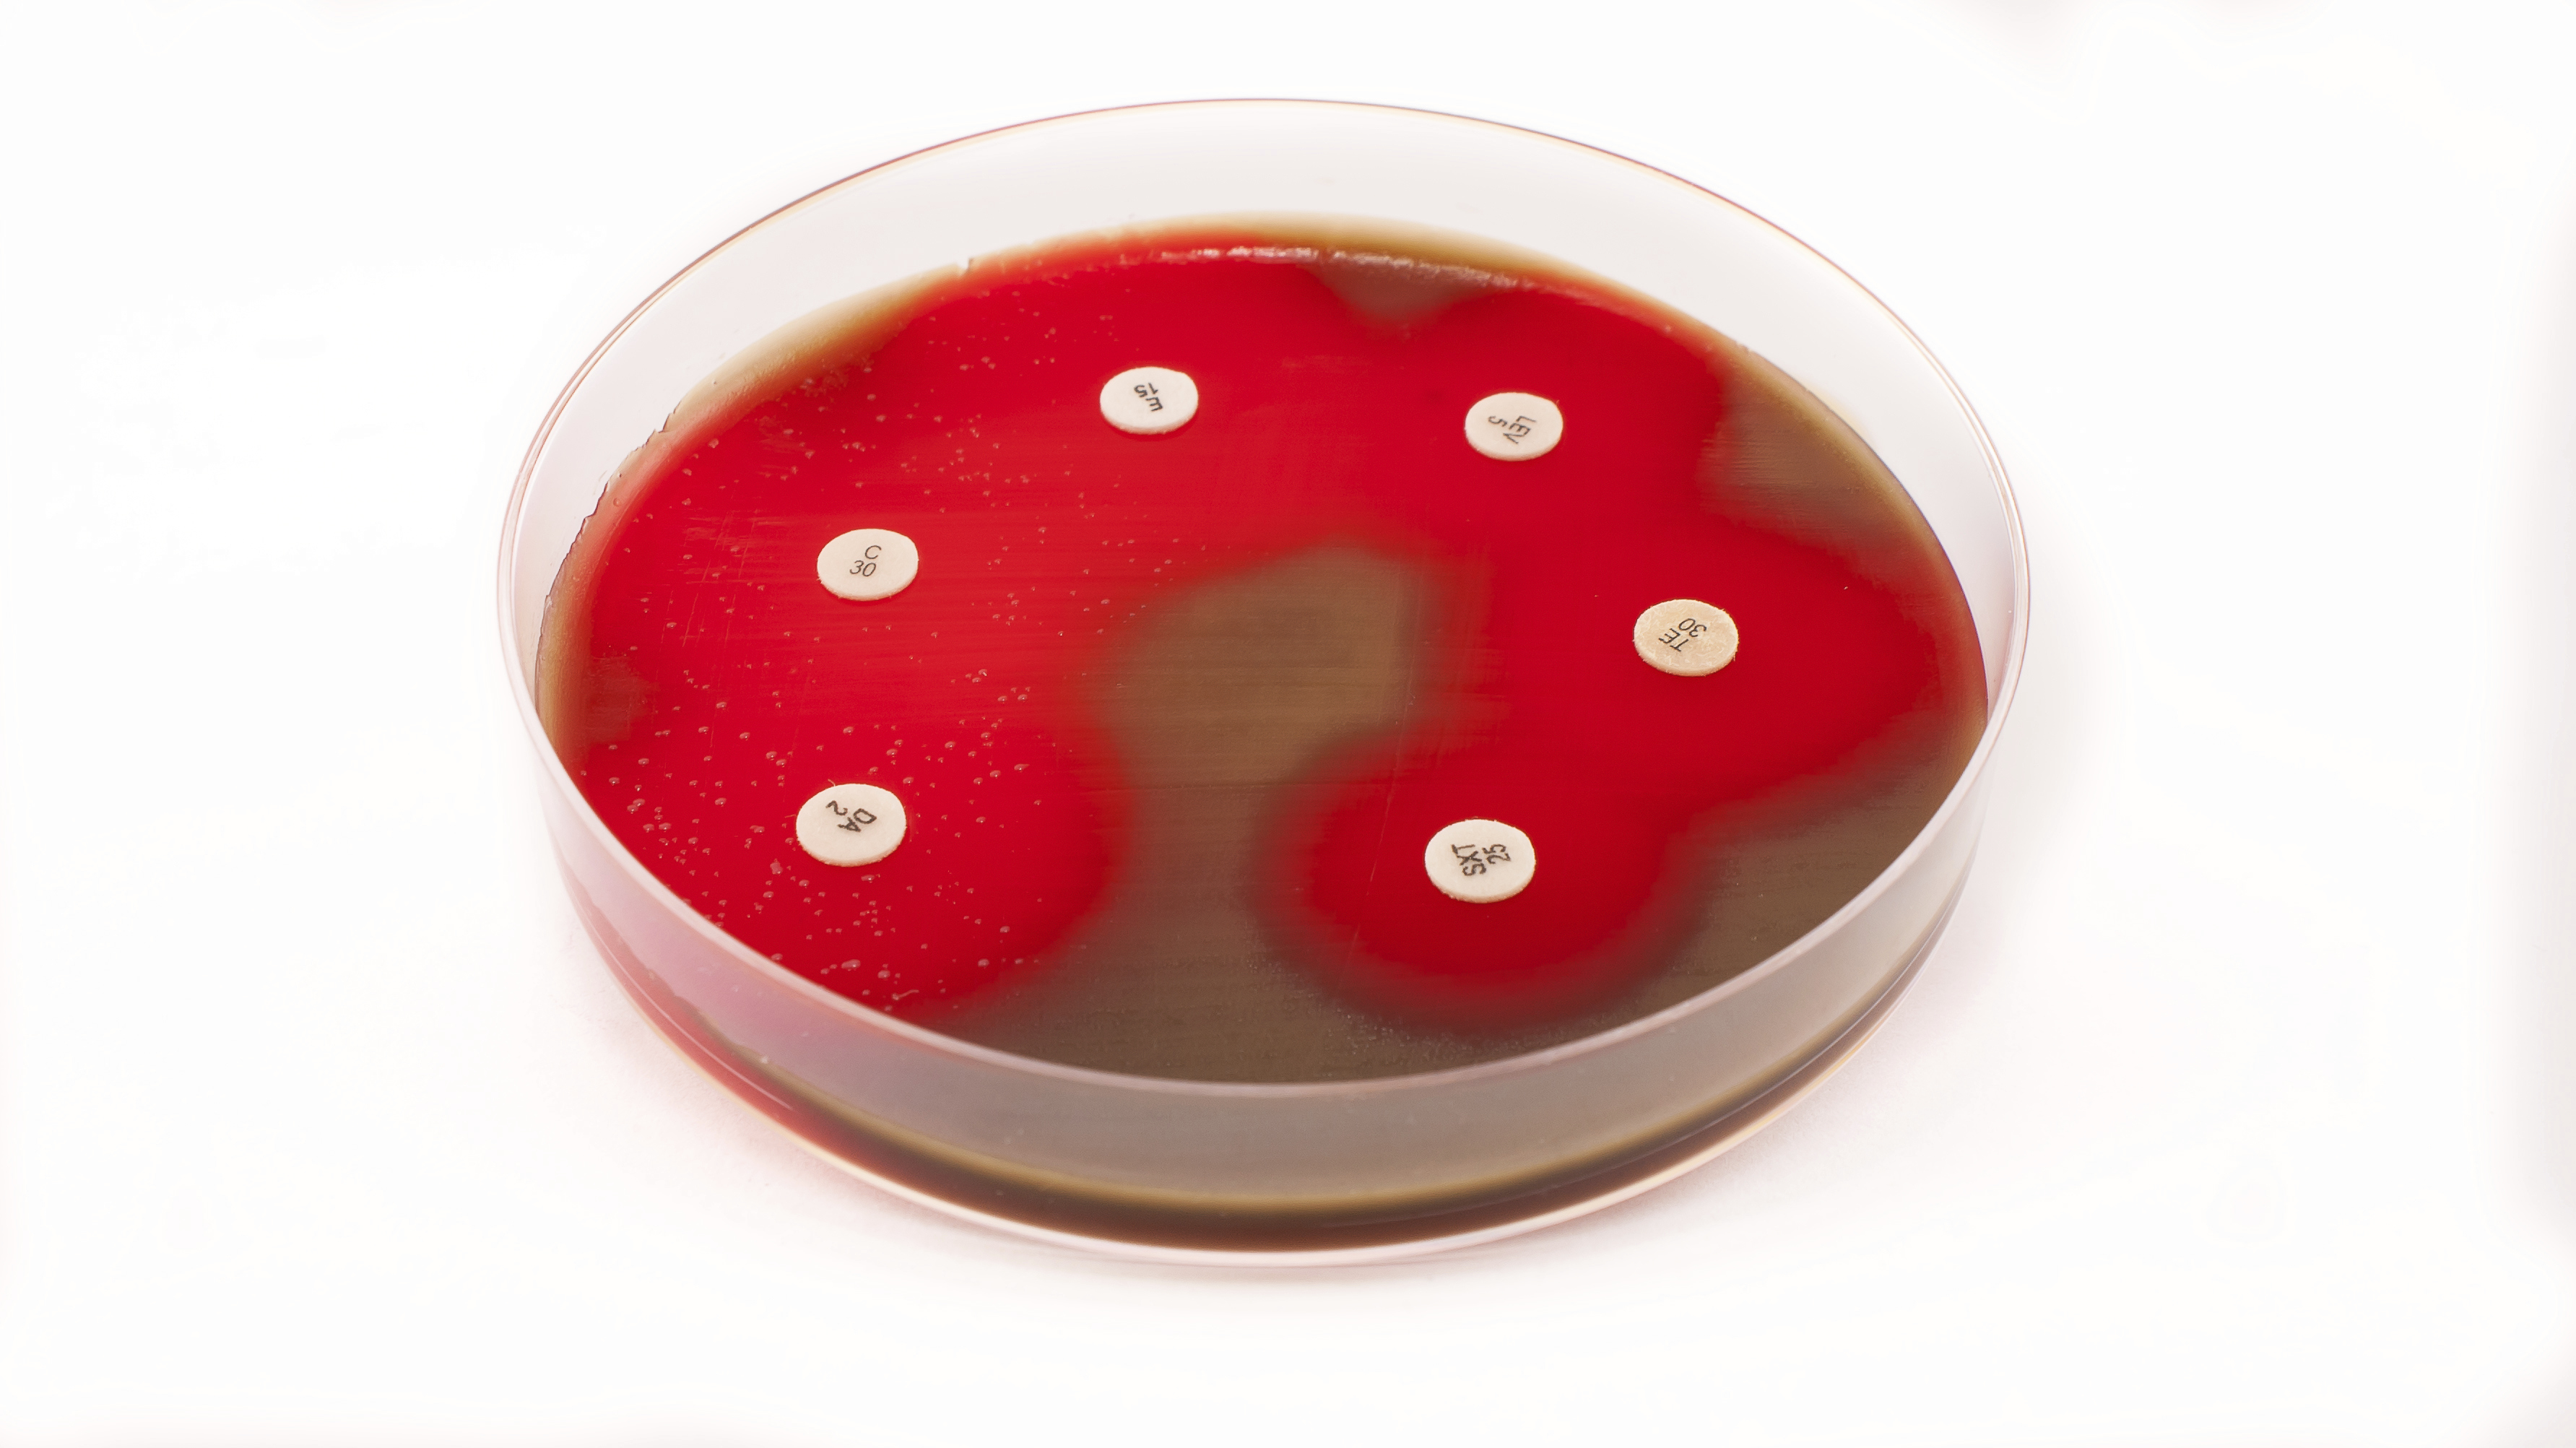
Meningite stafilococcica

Cos'è la meningite stafilococcica
La
stafilococcica è una forma di
meningite, dovuta al batterio stafilococco, che interessa le meningi, le membrane che avvolgono il cervello e il midollo spinale.
Come tutte le infezioni di origine batterica, la presenza di batteri nel liquor (liquido cerebrospinale) conferisce a quest’ultimo un tipico aspetto torbido, per questo motivo la meningite stafilococcica è caratterizzata dalla presenza di liquor torbid. Tale patologia può essere mortale.
Cause della meningite stafilococcica
La principale causa di meningite
stafilococcica sono gli agenti patogeni S. aureus ed S. epidermidis. Tra le altre cause spiccano i traumi cranici e gli interventi chirurgici; la meningite stafilococcica, inoltre, può essere la conseguenza di una osteomielite o anche di un ascesso cerebrale, di una infezione diffusasi nel sangue da un altro sito.
I fattori di rischio includono:
- Pregresse infezioni del cervello o meningite associata a shunt del liquido spinale;
- Recente intervento chirurgico al cervello
- Infezioni delle valvole cardiache
- Infezioni del sangue
Sintomi di meningite stafilococcica
I principali sintomi che si avvertono quando si è affetti da
meningite stafilococcica sono:
- confusione
- febbre
-
nausea e vomito
- sfoghi cutanei
- fotofobia
- mal di testa
- torcicollo
Diagnosi della meningite stafilococcica
La meningite stafilococcica viene diagnosticata sia mediante la valutazione della sintomatologia, sia tramite un esame fisico volto a cercare eventuali rapide frequenze cardiache e un abbassamento della pressione sanguigna. Tale patologia può essere diagnosticata anche mediante degli esami quali esami del sangue, le analisi del liquido spinale e la conta dei globuli bianchi.
Cure per la meningite stafilococcica
La
meningite stafilococcica viene trattata mediante la somministrazione di antibiotici come la teicoplanina o la vancomicina.
Prognosi della stafilococcica
La
prognosi della meningite stafilococcica è, purtroppo, spesso negativa in quanto, di frequente e se non trattata tempestivamente, può provocare la morte.